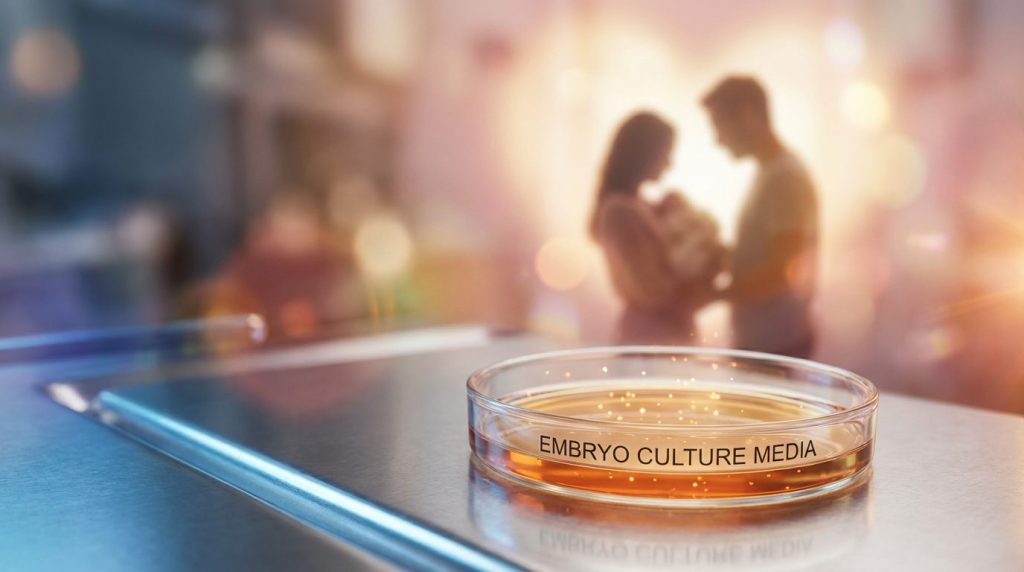
不妊治療の成功を支える「培養液」とは? 6 3XHgtQLn

役割、種類、そして国産化への道筋
近年、不妊に悩むカップルにとって、生殖補助医療(ART)は大きな希望となっています。その中心にある体外受精(IVF)は、多くの家族に新しい命をもたらしてきました。
そして、その高度な医療技術を陰で支えている重要な存在が、培養液です。
体外に取り出された卵子と精子が出会い、受精卵となり、胚へと成長していく。その最初の数日間、胚は培養液の中で過ごします。
培養液は単なる液体ではありません。胚にとっては、お腹の中に近い環境を人工的につくるための生命の基盤です。
この記事では、培養液の役割と種類を整理しながら、現在の培養現場で主流となっている考え方、さらに日本の市場が輸入品に大きく依存している背景と今後の展望について解説します。

第1章:培養液の役割
胚を育む「生命の水」
体外受精において、採卵された卵子や受精卵は通常5〜6日間、場合によってはそれ以上、体外で培養されます。その間、胚が接している環境のほぼすべてが培養液です。
つまり、培養液の質は治療成績に直結するといっても過言ではありません。
体内環境をできるだけ忠実に再現する
自然妊娠では、受精は卵管で起こり、その後、受精卵は分割を繰り返しながら子宮へ移動していきます。
この間、胚は卵管液や子宮内液に満たされた環境の中で育ちます。
培養液のもっとも大きな役割は、この卵管や子宮の中に近い環境を体外で再現することです。
本来なら母体内で守られているはずの胚を、体外という不利な環境の中でもできるだけストレスなく育てる。そのために培養液は設計されています。
胚の成長に必要な栄養を供給する
培養液には、胚が細胞分裂を繰り返し、着床可能な胚盤胞まで発育するために必要な成分が含まれています。
エネルギー源となる乳酸、ピルビン酸、グルコース、さらにアミノ酸や塩類などがその代表です。
胚は見た目には小さな細胞の集まりですが、その中では非常に精密な代謝や分化が進んでいます。培養液は、その変化を支えるための栄養の土台でもあります。
物理化学的な安定を保つ
培養液の役割は栄養補給だけではありません。
胚が健やかに育つためには、pH、浸透圧、温度、湿度、酸素濃度、二酸化炭素濃度などが厳密に管理される必要があります。
培養液は、そうした条件の急激な変化から胚を守る緩衝環境としても機能します。
つまり培養液は、「栄養」と「環境安定」の両方を担う存在なのです。

第2章:培養液の主要な種類と現在の主流
施設ごとに選択は異なるが、現在はワンステップ培養液が主流
体外受精で用いられる培養液は、使用方法によって大きく
**シーケンシャルメディウム(二段階培養法)**と
シングルステップメディウム(一段階培養法)
の2つに分けられます。
ただし、現在の臨床現場では、ワンステップ培養液(シングルステップメディウム)が主流になっています。
かつては、胚の発育段階ごとに必要な栄養が違うという考えに基づき、途中で培養液を切り替えるシーケンシャルメディウムが広く使われてきました。
しかし近年は、ワンステップ培養液そのものの培養成績が向上してきたことに加え、タイムラプスインキュベーターの普及も後押しとなり、培養液交換を行わない運用が一般的になっています。
シーケンシャルメディウム(二段階培養法)
シーケンシャルメディウムは、胚の発育段階ごとに必要な環境が異なるという発想に基づく方法です。
受精後まもない初期胚と、その後に胚盤胞へと進む段階では、利用するエネルギー源や必要な栄養成分が変化すると考えられています。
そのためこの方法では、初期胚用の培養液と胚盤胞用の培養液を使い分けます。一般的には培養3日目頃に、培養液を交換して胚を移し替えます。
この方法の利点は、各発育段階に応じた環境を細かく整えやすいことです。
一方で、培養液交換の際には胚を一度インキュベーターから取り出す必要があるため、温度変化やpH変動、光曝露などのストレスがかかる可能性があります。
理論としては非常に整った方法ですが、現在の現場では、この方法を標準として採用している施設はかなり限られてきています。
シングルステップメディウム(一段階培養法)
シングルステップメディウムは、培養期間を通じて1種類の培養液を使い続ける方法です。現場では「ワンステップ培養液」と呼ばれることが多く、現在はこちらが主流です。
考え方としては、胚は周囲に存在する成分の中から、自ら必要な栄養素を選択的に取り込みながら発育できる、というものです。
そのため、初期胚から胚盤胞までに必要な成分をあらかじめ1つの培養液に含ませておけば、途中で交換しなくても培養可能だと考えられています。
この方法の最大の利点は、培養液交換が不要なため、胚を外部環境の変化にさらす回数を減らせることです。
これは、タイムラプスインキュベーターとの相性の良さにも直結します。胚を外に出さずに連続観察できるタイムラプスと、培養液交換を必要としないワンステップ培養液は、非常に合理的な組み合わせです。
さらに実際の培養現場では、培養液交換なしで同等、あるいはそれ以上の成績が得られるなら、利便性の面からもワンステップを選ぶという判断が自然です。
培養士にとって、操作回数が少なく、安定した環境で胚を管理できることは大きなメリットです。
どちらが優れているのか
この問いに対して、単純に「こちらが絶対に優れている」と言い切ることはできません。
理論面では両者にそれぞれ強みがあり、研究報告でも胚盤胞到達率や妊娠率に統計的な有意差がないとするものがあります。
ただ、実際の臨床現場で重視されるのは、理論上の優劣よりも、
その施設の設備・運用・観察体制の中で、安定して良い成績が出せるかどうかです。
その観点から見ると近年は、
- 胚へのストレスを減らせる
- 培養操作を簡便化できる
- タイムラプスとの親和性が高い
- 培養液そのものの性能が向上している
といった理由から、ワンステップ培養液が主流となっています。
現在の現場を正確に伝えるなら、
シーケンシャルという考え方は今も重要だが、実際の主流はワンステップである
と整理するのが自然です。

第3章:日本の培養液市場
なぜ輸入品が多いのか
日本の不妊治療技術は世界的にも高水準ですが、その治療を支える培養液の多くは海外製品に依存しています。
この背景には、医療分野特有の複数の要因が複雑に絡み合っています。
開発と製造の参入障壁が高い
培養液は、人の生命の始まりを支える極めて繊細な製品です。
安全性や品質に対する要求は高く、関連する試験や規格への対応には膨大なコストと専門知識が必要です。
新しい製品を市場に出すためには、生物学的安全性評価や品質管理体制の構築など、多くのハードルを越えなければなりません。
しかも培養液市場は、決して巨大市場ではありません。
そのため、国内企業にとっては開発投資を回収できるかどうかが大きな壁になります。
海外大手メーカーの先行優位
培養液の分野では、長年にわたり世界市場をリードしてきた海外メーカーがあります。
こうした企業は豊富な研究開発の蓄積と臨床実績を持ち、多くのクリニックから信頼を得ています。
不妊治療施設にとって最優先なのは、当然ながら治療成績です。
そのため、新規性よりも、長年の使用実績があり、安定した結果が報告されている製品が選ばれやすくなります。
この傾向が、輸入品中心の市場構造をさらに強めています。
国際情勢や物流の影響を受けやすい
輸入品依存は、安定供給という点で脆さも抱えています。
国際物流の混乱や為替変動、関税などの影響を受けやすく、結果的にコスト上昇が治療現場や患者負担に跳ね返る可能性があります。
つまり、日本の培養液市場は、
技術は高いのに基盤資材は海外依存
という構造を抱えているのです。
国産化への挑戦
とはいえ、国産化の動きがまったくないわけではありません。
国内メーカーによる不妊治療用培養液の開発・販売や、培地関連の周辺分野における日本企業の取り組みも進んでいます。
本気で医療の安定供給や経済安全保障まで考えるなら、培養液のような基盤資材は、国内での研究・開発・供給体制を強くしていく必要があります。
今後、関連技術の蓄積が進めば、高品質な国産培養液の存在感がさらに高まる可能性は十分あります。

第4章:培養液をめぐる最新動向と今後の展望
培養液は完成された技術ではありません。今も改良が続いています。
高機能化する培養液
近年の培養液は、単なる栄養補給のための液体ではなく、胚の発育をよりよく支えるための機能を持たせる方向へ進んでいます。
たとえば、胚へのストレスを和らげる抗酸化物質、発育を支える成長因子の添加、さらに移植時の着床環境を意識した高濃度ヒアルロン酸含有培養液などが注目されています。
また、胚盤胞を培養していた培養液に由来する成分を利用して子宮内環境を整えるSEET法のような技術もあり、培養液は「培養するための液体」から、「妊娠成立を支援する戦略の一部」へと位置づけが広がってきています。
保険適用と費用の問題
2022年4月から体外受精を含む不妊治療の保険適用が始まりましたが、すべての技術が保険でカバーされるわけではありません。
高濃度ヒアルロン酸含有培養液を用いた前処置は加算対象となる一方、SEET法やタイムラプス培養などは先進医療扱いになることが多く、患者は保険診療と組み合わせて選択することになります。
技術が増えれば増えるほど、患者にとっては何を選ぶか、どこまで費用をかけるかという判断も難しくなります。
個別化医療への期待
将来的には、患者ごとの背景や胚の特性に応じて、より適した培養液や培養戦略を選ぶ方向へ進んでいく可能性があります。
特定の患者や胚の状態によっては、あるメーカーの培養液が他より良い結果をもたらすといった、いわば「胚と培養液の相性」のような視点も示唆されています。
もしここにAI解析やデータ統合が本格的に入ってくれば、
「どの患者に、どの培養条件が合いやすいか」
をより精密に見極める時代が来るかもしれません。
結論
不妊治療における培養液は、単なる補助的な資材ではありません。
それは、**体外での生命の始まりを支える“環境そのもの”**です。
そして現在の現場を正しく伝えるなら、次の点は明確にしておく必要があります。
- シーケンシャルメディウムは、発育段階に応じて環境を整えるという理論的に重要な考え方を持つ
- ただし、現在の実臨床ではワンステップ培養液が主流である
- その背景には、タイムラプスの普及だけでなく、ワンステップ培養液そのものの成績向上がある
- 利便性、運用性、胚へのストレス軽減という現場の合理性が、主流の変化を後押ししている
培養液を理解することは、不妊治療を支える見えない技術基盤を理解することでもあります。
そしてその理解は、患者にとっても、医療者にとっても、より納得感のある治療選択につながっていくはずです。
監修して頂きましたのは今野 彰氏(ASKAレディースクリニック培養室長)です。

生殖医療のかなり早い段階からの胚培養士で、婦人科だけではなく泌尿器科との連携なども積極的に実施してこられた先駆者のお一人。
胚培養士の仕事をしつつも男性の患者さんに寄り添うために看護師資格も取得し、幅広い視野で生殖医療をささえておられます。
履歴
1994年 神戸大学 農学部 畜産学科卒業
1997年 神戸大学大学院自然科学研究科卒業(応用動物学専攻)
越田クリニック培養室勤務
2010年 ASKAレディースクリニック培養室長
●取得資格
日本不妊カウンセリング学会認定不妊カウンセラー
日本卵子学会認定胚培養士
准看護士免許
参考リンク
日本の生殖補助医療市場規模、動向及び2034年までの予測胚培養液について|ブログ|医療法人社団 晴晃会
受精卵を育てる培養液とはどんなもの?(2018年4月)培養液について|不妊治療 京野アートクリニック高輪(東京)
【基礎内容】培養液について①|メディカルパークみなとみらい新しいIVF培養液の開発幹細胞培養上清液とは?
再生医療由来の新たな自由診療生物学的安全性評価の審査ポイント|独立行政法人 医薬品医療機器総合機構関連資料
Ⅵ8. 医療機器業界が注目すべき外部環境の変化世界の体外受精市場 – 業界動向と2029年までの予測不妊治療の世界市場レポート2025年有価証券届出書(新規公開時)-
EDINET島津製作所、細胞培養の培地開発を効率的に AIスタートアップ活用不妊治療の保険適用について(周知)
【2025年最新】体外受精の費用はいくら?保険適用・助成制度体外受精に実際かかる費用はいくら?内訳や概算費用
研究成果最適展開支援プログラム A-STEP|評価結果Embryo Culture Media – Nashville Fertility Clinic – IVFSingle versus sequential culture medium: which is better at …

